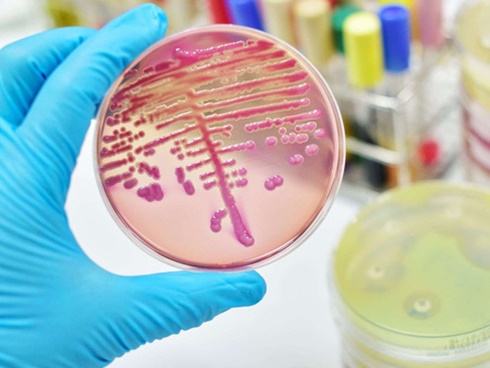
Cảnh báo: Đã có trường hợp tử vong do nhiễm chủng nấm mới siêu mạnh đang hoành hành khắp toàn cầu-5

Điều đáng lo ngại nhất là siêu vi khuẩn nấm Candida auris này kháng với ít nhất một loại thuốc trị nấm, khiến cho bác sĩ chỉ còn lại một vài lựa chọn khi điều trị cho bệnh nhân.
Bà Stephanie Spoor, 64 tuổi ở Chicago, bang Illinois (Mỹ), được chẩn đoán nhiễm nấm Candida auris và qua đời không lâu sau khi nhập viện.
Bà Stephanie Spoor được đưa tới bệnh viện tháng 11 năm ngoái với triệu chứng mà bà cho rằng mình bị nhiễm trùng xoang. Nhưng 3 tuần sau, biện pháp điều trị ngày càng trở nên không có hiệu quả, sức khỏe của bà, tiếp tục suy giảm.
Bệnh nhân được chuyển tới phòng chăm sóc đặc biệt tại Trung tâm Y tế Đại học Rush. Tại đây, bác sĩ phát hiện Stephanie Spoor đã bị nhiễm Candida auris - một bệnh nhiễm trùng do siêu vi khuẩn nấm kháng thuốc.

Stephanie Spoor và chồng là Gregory. Stephanie Spoor đã chết sau khi được báo cáo nhiễm Candida auris trong bệnh viện.
Điều đáng lo ngại nhất là chủng Candida auris kháng với ít nhất một loại thuốc trị nấm, khiến cho bác sĩ chỉ còn lại một vài lựa chọn khi điều trị bệnh nhân.
Chủng nấm mới được phát hiện này có thể lưu lại trên da người một thời gian dài và có thể lây lan gián tiếp giữa những người có hệ miễn dịch yếu.
"Như thể một phòng thí nghiệm"
Chồng bà Stephanie Spoor, Greogry Spoor, 67 tuổi, được bác sĩ thông báo rằng, bệnh nhiễm trùng có thể đã xâm nhập máu vợ mình qua một ống thông hay đường truyền tĩnh mạch trong quá trình điều trị tại bệnh viện.
Con trai họ, Nicholas, 40 tuổi, cho biết, ngày mẹ được chẩn đoán nhiễm nấm Candida auris, anh nhận thấy, các nhân viên y tế được trang bị lớp phủ bảo vệ quần áo toàn vẹn và găng tay. Họ cũng sử dụng thuốc tẩy để rửa sạch chân khi bước vào và rời khỏi phòng. Tất cả mọi thứ đều mang một lớp trắng do các hóa chất được dùng để vệ sinh chúng. "Căn phòng giống một phòng thí nghiệm vậy", Nicholas chia sẻ với tạp chí Times.
Không từ bỏ hi vọng
Gia đình Spoor vẫn nuôi hi vọng về khả năng tiến triển của bà Stephanie khi bác sĩ cho biết, chủng nấm này đang được khống chế bởi loại thuốc điều trị mà bệnh viện sử dụng. Họ "mong chờ loại nấm này sẽ được quét sạch khỏi cơ thể người bệnh".
Nhưng bất chấp những nỗ lực để tiêu diệt chủng nấm cứng đầu, Candida auris vẫn tiếp tục trở lại và cướp đi tính mạng của bà Stephanie Spoor. Giấy chứng tử của bà có ghi nguyên nhân tử vong là suy hô hấp.
Nicholas kể: "Candida auris là thứ mà chúng tôi thậm chí còn không biết nó có tồn tại. Và rồi nó xảy ra. Đó là một trong những nguyên nhân chủ yếu khiến mẹ tôi thiệt mạng".

Bà Stephanie khi còn trẻ.
Sự hoành hành của loại siêu vi khuẩn nấm giết người
Trong vòng 5 năm qua, Candida auris đã tấn công các trung tâm y tế trên toàn thế giới, bao gồm cả khoa sơ sinh ở Venezuela và một bệnh viện ở Tây Ban Nha.
Năm 2015, Candida auris xuất hiện tại Anh với việc khoa chăm sóc đặc biệt của Bệnh viện Hoàng gia Brompton ở London buộc phải đóng cửa 11 ngày sau khi đợt bùng phát.

Ở Mỹ, đã có 587 trường hợp nhiễm loại nấm trên được ghi nhận, chủ yếu ở New York, New Jersey và Illinois. Thực trạng này khiến Cơ quan Phòng ngừa và Kiểm soát Dịch bệnh Hoa Kỳ (CDC) phải bổ sung Candida auris vào danh sách "những mối đe doạ khẩn cấp".

Gần như toàn bộ mẫu vật từ 51 bệnh nhân ở các cơ sở y tế tại New York đều kháng fluconazole, một loại thuốc kháng nấm phổ biến.
|
Candida auris là gì? Candida auris là một loại nấm, mà khi thâm nhập máu, có thể gây các bệnh nhiễm trùng nguy hiểm, đe doạ tính mạng người bệnh. Những người có hệ miễn dịch yếu, đặc biệt, những người đã ốm sẵn, người cao tuổi và trẻ sơ sinh là đối tượng dễ bị nhiễm nấm Candida auris. Loại nấm này lần đầu tiên được phát hiện ở một bệnh nhân tại Nhật vào năm 2009. Candida auris có thể kháng với các loại thuốc chính sử dụng để kháng nấm. Điều này đồng nghĩa với việc nó có thể gây tử vong trong một số trường hợp. Hiện tại, CDC đang tích cực nghiên cứu đặc điểm di truyền để hiểu rõ cách thức ngăn chặn sự lây lan của nấm Candida auris. Thời báo Times khẳng định, đây là một thử thách không hề nhỏ. |
Theo Helino